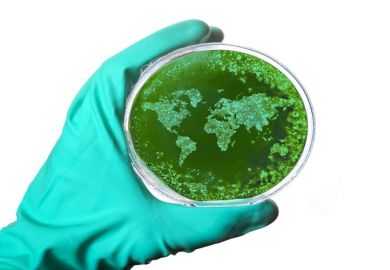

African academics should not fear the recruitment of remotely based Western academics as these experts can help to build institutional expertise in strategically important areas, a Ghanian university leader has insisted.
Patrick Awuah, president of Ashesi University, a private not-for-profit university in Ghana, told the Reinventing Higher Education conference in Rome that his institution was looking to hire international specialists to teach in areas such as artificial intelligence who would not consider a move to west Africa.
It follows the success of similar virtual learning sessions during the pandemic that had helped to make his institution “much more connected to the world” even while national borders were shut, explained Mr Awuah at the event at Luiss Guido Carli, held in association with Madrid’s IE University.
“We now can hire someone to teach virtually who might not think about moving to Ghana,” said Mr Awuah, a former software engineer at Microsoft who founded Ashesi University in 2002, having studied and lived in the US for more than a decade.
“We had more students taking international classes [in the pandemic] and hired more international faculty to teach our students – we will continue to reach out to the global marketplace to hire people who might not have thought about coming to us.”
Virtual teaching in these difficult-to-teach areas should also be supplemented by personal assistance from African academics who, in Ashesi’s case, were being mentored by the Western academics hired by the university, he said.
“In-person classes are much preferred by students, but this is all about building up our capacity,” said Mr Awuah, who added that without these Western staff “there would be no classes at all”.
“Being able to partner with these experts really helps to strengthen our faculty over time – we are now offering a master’s in AI, which will depend on local and remote staff, including virtual and face-to-face teaching,” he said.
Knowing how to blend virtual and face-to-face teaching was also crucial for Western universities, said Alice Gast, president of Imperial College London.
“Students want to interact face to face with lecturers and want to be engaged,” said Professor Gast, who urged more staff to adopt the flipped classroom approach of placing lectures online and devoting contact hours to responding to student questions.
“Lectures are not the best way [to teach] – they are the easiest way to control the room and talk about what you know. With flipped learning, you spent times diving into questions, and that is the opportunity that we have now,” said Professor Gast.
Register to continue
Why register?
- Registration is free and only takes a moment
- Once registered, you can read 3 articles a month
- Sign up for our newsletter
Subscribe
Or subscribe for unlimited access to:
- Unlimited access to news, views, insights & reviews
- Digital editions
- Digital access to THE’s university and college rankings analysis
Already registered or a current subscriber?